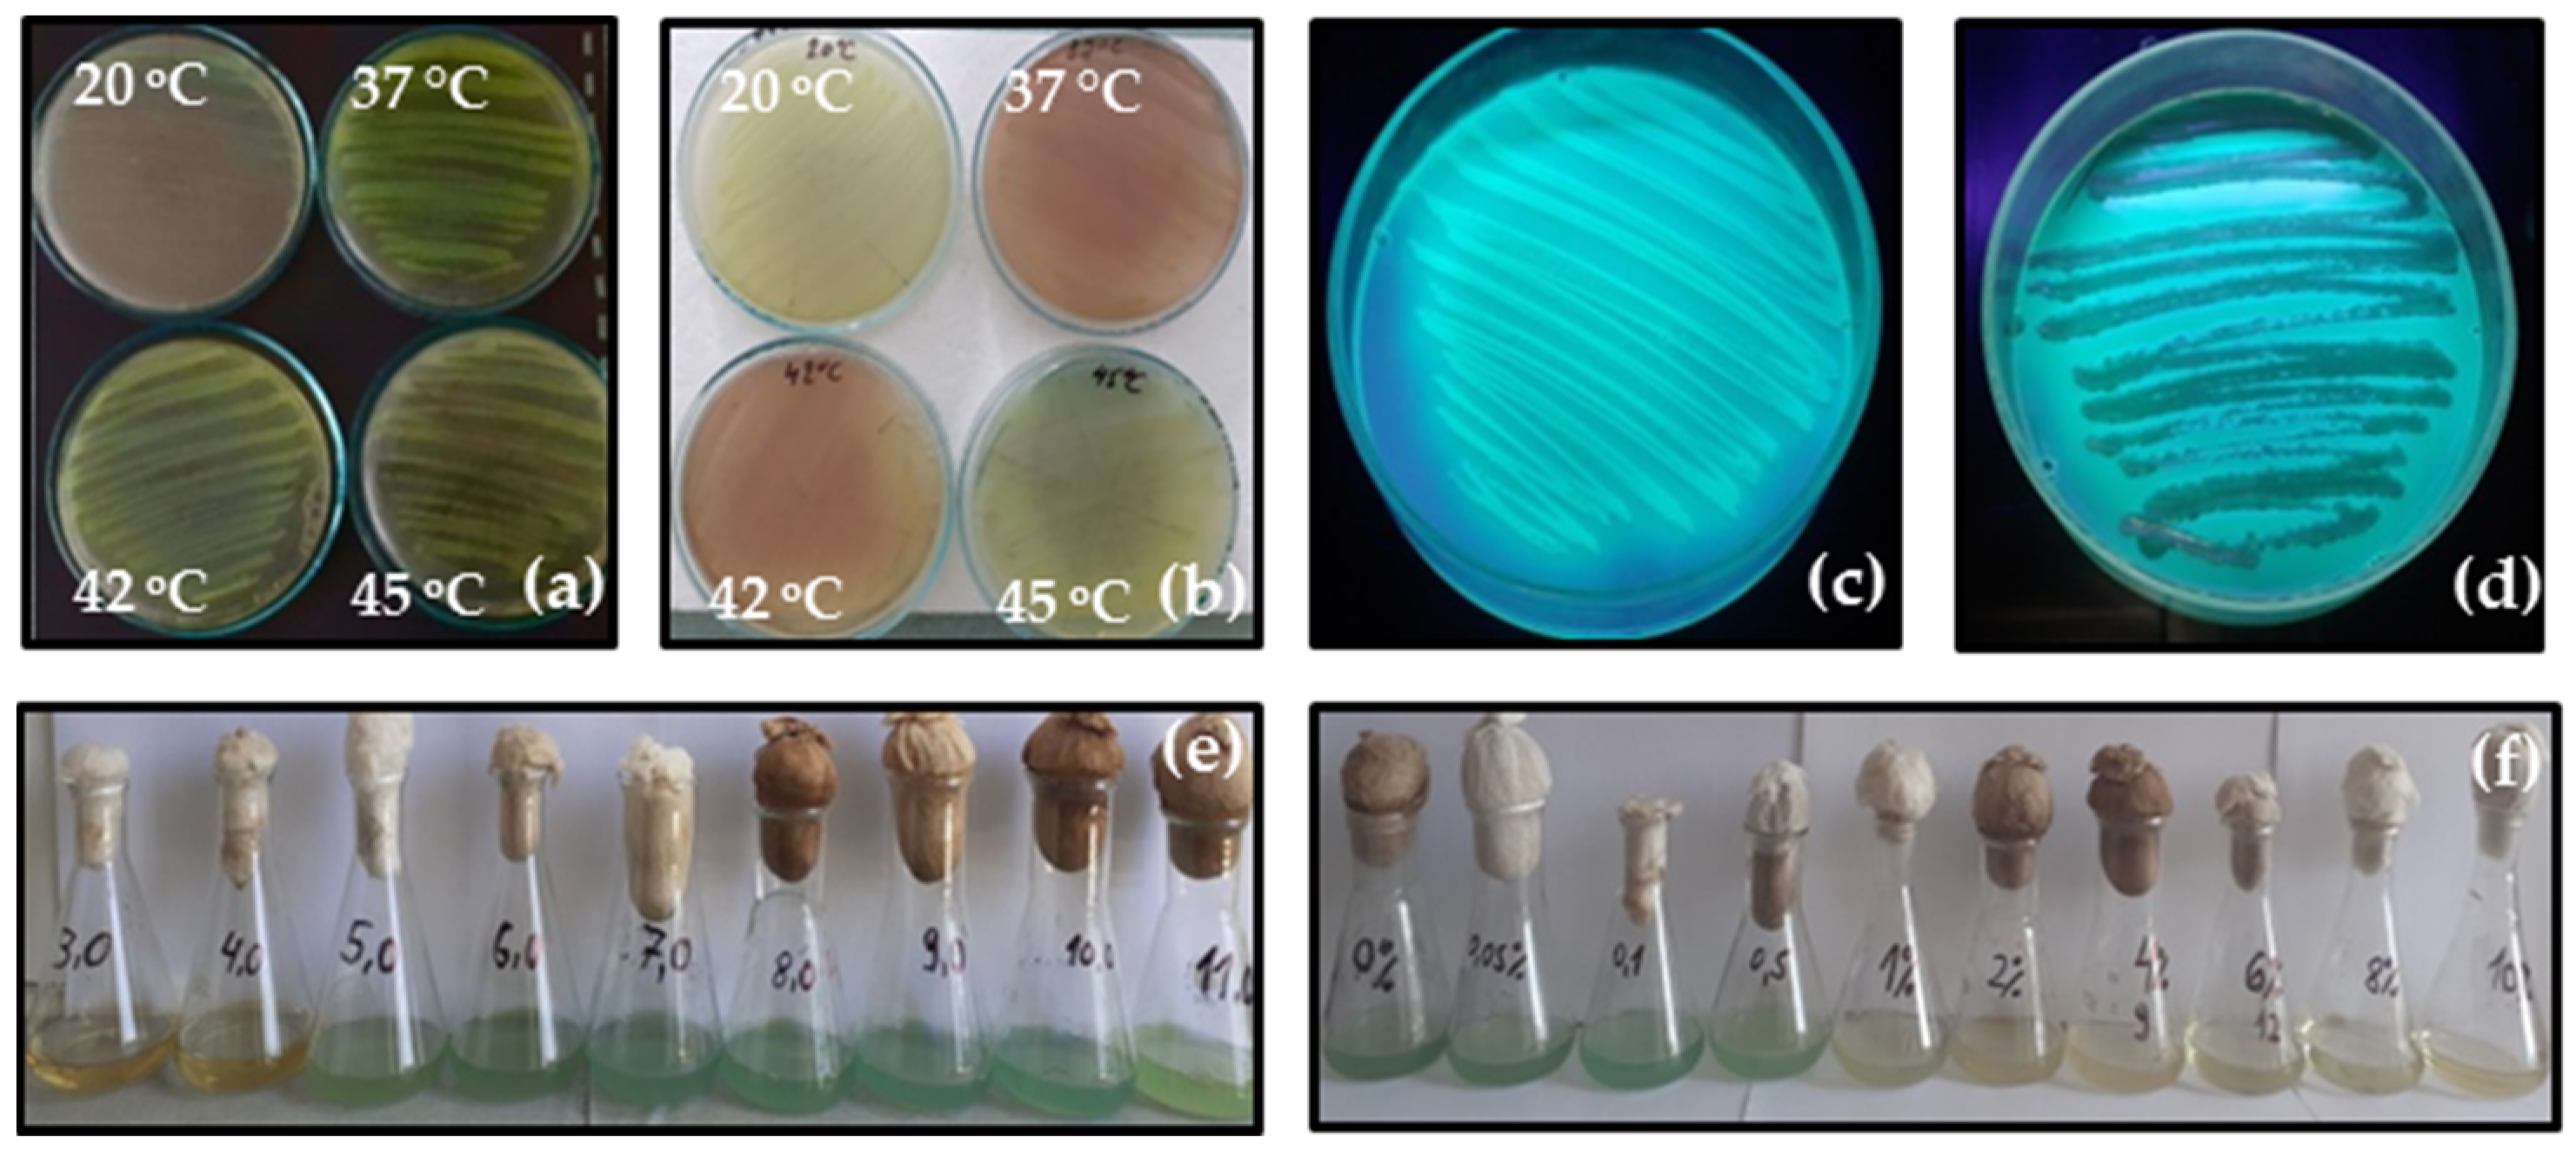
Applmicrobiol 04 00096 g004

Abstract
Pseudomonas aeruginosa is a ubiquitous environmental Gram-negative bacterium and also an opportunistic pathogen for both humans and animals, causing acute or chronic infections. It has been frequently detected in healthy and diseased reptiles, more commonly in captive ones. Since most studies are primarily on clinical isolates, the pathogenic potential of strains originating from wild animals is poorly explored. We isolated the strain P. aeruginosa PM1012 from the cloacal microbiota of a common wall lizard (Podarcis muralis Laurenti, 1768) from a free-living population. The effect of temperature, pH and salinity on its growth was evaluated. Antibiotic resistance, the expression of several virulence factors as some extracellular enzymes, pyocyanin production and biofilm formation were also assessed. Apart from intrinsic resistance, the newly isolated strain P. aeruginosa PM1012 presented an antibiotic susceptibility profile with a low resistance rate limited to meropenem and intermediate to ceftazidime and aztreonam. Protease, lipase and gelatinase secretion was detected. Strong pyocyanin production was observed in the optimal range of growth conditions. An excellent biofilm-forming capacity was manifested.
1. Introduction
Pseudomonas aeruginosa is a Gram-negative, facultatively aerobic, non-spore-forming, rod-shaped bacterium that is commonly found in soil, water and many human/animal-impacted habitats [1]. Its genomic and metabolic flexibility allows it to adapt to and thrive in a wide range of environments and nutrient sources [1,2]. As an opportunistic pathogen, it can be implicated in infections in diverse hosts, including plants, animals and humans [3,4,5,6,7]. P. aeruginosa can cause a wide array of infections in the respiratory system, urinary tract, skin, blood stream, soft tissues, ear, traumas, burn wounds, etc. [8], immunocompromised individuals with chronic obstructive pulmonary disease (COPD), cystic fibrosis, cancer or AIDS being particularly vulnerable [7]. This microorganism is considered one of the most clinically important Gram-negative bacteria, responsible for about 10 to 20% of nosocomial infections worldwide and 50% fatality [9,10]. Over 500,000 deaths worldwide annually are attributable to P. aeruginosa [11]. The high mortality rate and difficulty in eradicating pseudomonad infections are due to the inactivation of antibiotics, the modification of drug targets, the attenuation of membrane permeability, the effectiveness of efflux systems, biofilm formation and quorum sensing, which all together contribute to the low efficacy of many antimicrobials [9]. P. aeruginosa is in the group of six so-called “ESKAPE” bacteria for which the arsenal of therapeutics is limited due to their capacity to become increasingly resistant to all available antibiotics [4].
Despite their capability to colonize both humans and animals, P. aeruginosa infections of animal origin are relatively less documented because P. aeruginosa is more often considered an environmental contaminant rather than a true pathogen [4]. In veterinary pathology, P. aeruginosa is responsible for a wide range of infectious diseases, including keratitis, chronic otitis media and otitis externa, conjunctivitis, pneumonia, endocarditis, urinary tract infections, septicemia, pyoderma, endometritis, etc., in various species of companion and farm animals [4,5,12]. P. aeruginosa is the leading cause of canine otitis, affecting up to 20% of dogs worldwide, and in some cases, it requires the surgical removal of the external ear canal and partial removal of the middle ear, resulting in almost total hearing loss [13]. Outbreaks have been reported in mink fur farms, where P. aeruginosa appears to be particularly virulent, clinically manifesting as fatal hemorrhagic pneumonia, killing up to 75% of individuals in some cases [14,15]. In ruminants, this pathogen could be responsible for mild-to-severe mastitis that may occur sporadically or epidemically within dairy herds, with a mortality rate of approximately 10% observed in cases of gangrenous mastitis in goats and sheep [16]. This pathogen has been associated with high mortality in the poultry industry as well [17]. In reptiles, P. aeruginosa is frequently present in the oral and cloacal microbiota, both in clinically healthy and symptomatic individuals [18,19,20]. It is more commonly detected in captive animals than in free-living ones, possibly due to inappropriate rearing conditions and stress that predispose them to the development of infections [20,21]. Pseudomonas has been proven to be the causative agent for dermatitis; stomatitis; cloacitis; abscesses; ear and respiratory infections and septicemia, associated with high morbidity and mortality in ophidians, chelonians and saurians [19,21,22,23,24]. The treatment of P. aeruginosa infections is often difficult due to the high occurrence of antibiotic resistance to different antibiotic classes and the prevalence of multidrug resistance (MDR) strains [12,20,21,25,26,27,28,29]. However, studies addressing the problem of antibiotic resistance in wild-type strains in animals that have not been exposed to an antibiotic-manipulated environment are scarce. Antimicrobial resistance and virulence should be closely monitored in P. aeruginosa isolates derived from animals in line with possible transfer or dissemination among different ecological niches [30]. Humans can also become infected with Pseudomonas from pet reptiles through bite wounds, scratches or the inhalation or ingestion of the microorganisms excreted in feces [18]. There is a paucity of data regarding the prevalence of P. aeruginosa in free-ranging reptiles. In the view of the One Health concept, which outlines the connection between human, animal and environmental health, screening for pathogens in animals in their natural habitat is recommended. We isolated and identified a wild-type strain of P. aeruginosa from the cloacal microbiota of a common wall lizard (Podarcis muralis Laurenti, 1768) originating from a population inhabiting a non-urbanized area in Bulgaria. The aim of this study was to investigate the effect of some environmental conditions on the growth of the strain and to determine its antibiotic resistance and phenotypical expression of some virulence factors—extracellular enzymatic activity, pyocyanin production and biofilm formation. In general, research on the microbiota of reptiles highlighting this aspect is scarce.
2. Materials and Methods
2.1. Isolation and Identification
P. aeruginosa PM1012 was isolated from the cloacal microflora of a common wall lizard (P. muralis Laurenti, 1768) within a survey on the endogenous microbiota of a wild-dwelling lizard population. The study area was located in the western part of Bulgaria, along the valley of the Dalbochitsa River, Ihtimanska Sredna Gora Mts, northeast of the village of Gabrovitsa (42°15′12″ N, 23°53′59″ E), 430–580 m above sea level. A total of 17 individuals of P. muralis were captured. The collection of cloacal samples was performed with sterile cotton swabs inserted carefully into the cloaca pre-wiped with 70% alcohol and with a gentle rotating motion. Cotton swabs were placed immediately in Amies transport medium (Biolab Inc., Budapest, Hungary) and stored at 4 °C for 48 h until further processing in a laboratory. All sampled animals were clinically healthy.
Cotton swabs were transferred into tubes with 5 mL Nutrient Broth (HiMedia Laboratories Pvt. Ltd., Mumbai, India) to enrich the cultures and incubated at 37 °C for 24–48 h depending on bacterial growth. The initial screening of the mixed cultures was performed by plating on Petri dishes with Cetrimide agar (Merck Group, Darmstadt, Germany)—a selective and differential medium for the isolation and identification of P. aeruginosa, incubated at 37 °C for 24 h. Suspect colonies were recultivated at 42 °C for another 24 h. Growth at 42 °C and a blue-green coloration due to the production of pyocyanin were reported as a presumptive identification of P. aeruginosa. Further phenotypic verification was performed microscopically (Gram staining) and biochemically by tests for catalase, glucose fermentation (OF test), cytochrome oxidase (OXI strip test), tryptophanase (INDOL test) and acetoin production (Voges-Proskauer reaction), all of them matching typical reactions for P. aeruginosa.
2.2. PCR Analysis
The genomic DNA of the presumptively identified isolate was extracted from a 24 h incubated NB culture, using the Illustra bacteria genomicPrep Mini Spin Kit (GE Healthcare, Chicago, IL, USA) and following the manufacturer’s instructions. The identification was based on the 16S region of the rRNA gene operon, which was amplified using the primers 27F (AGAGTTTGATCCTGGCTCAG) and 1492R (TACGGYTACCTTGTTACGACTT) [31]. For the experiment, PuReTaqTM Ready-To-GoTMPCR Beads (GE Healthcare, Chicago, IL, USA) were used. The mixture used for the PCR reaction was a final volume of 25 μL made up of 22 μL ultra-pure water, 1 μL of each primer (10 pmol) and 1 μL of extracted DNA template (8 ng). The amplification was achieved by 35 cycles of 95 °C (30 s), 57 °C (2 min), 72 °C (60 s), an initial denaturation at 95 °C (5 min) and a final extension step at 72 °C (10 min). Aliquots of 5 μL of reaction were analyzed on 1% (w/v) agarose gel in TBE buffer with an expected amplicon length of ~1400 bp. A 16S-amplified fragment was sequenced at Macrogen Inc. (Amsterdam, The Netherlands). Sequence data were edited using Bioedit version 7.2 [32]. For identification, 16S rRNA sequences were compared to NCBI (National Centre for Biotechnology Information) data using BLAST analysis [33].
2.3. Cultivation at Different Temperatures, pH and Salinity
The growth curves were performed at different temperatures, pH and salinity for a 24 h interval [34]. The effect of temperature was evaluated at 6 °C, 20 °C, 37 °C, 42 °C and 45 °C. The effect of pH was evaluated in the range of 3.0–11.0 during incubation at 37 °C and shaking speed 200 rpm. The effect of salinity was evaluated at 0%, 0.05%, 0.1%, 0.5%, 1%, 2%, 4%, 6%, 8% and 10% NaCl in the medium under the same conditions. Bacterial suspensions were prepared by adding 0.5 mL 18 h inoculum to 50 mL Nutrient Broth (HiMedia Laboratories Pvt. Ltd., Mumbai, India) in 100 mL Erlenmeyer flasks, resulting in a starting culture of 0.02 optical density (OD) 600 nm. Measurements were recorded by determining the absorbance of each sample (OD 600 nm), using Spectrophotometer UV-VIS 75 (Laborbio, Sofia, Bulgaria). Each experiment was performed in duplicate.
2.4. Antibiotic Susceptibility Testing (AST)
The susceptibility of the isolated strain was tested using the Kirby–Bauer disc diffusion method [35] against a broad panel of antibiotics: amoxicillin/clavulanic acid (AMC, 30 µg/mL), carbenicillin (CB, 100 µg/mL), ticarcillin (TI, 75 µg/mL), ticarcillin/clavulanic acid (TCC, 75/10 µg/mL), piperacillin/tazobactam (PIT, 30/6 µg/mL), cefotaxime (CT, 30 µg/mL), ceftriaxone (CFT, 30 µg/mL), ceftazidime (CAZ, 10 µg/mL), aztreonam (AT, 30 µg/mL), meropenem (MER, 10 µg/mL), amikacin (AM, 30 µg/mL), gentamycin (G, 10 µg/mL), tobramycin (TB, 10 µg/mL), pefloxacin (PF, 5 µg/mL), ciprofloxacin (CP, 5 µg/mL), levofloxacin (LE, 5 µg/mL), chloramphenicol (C, 30 µg/mL), tetracycline (T, 30 µg/mL), doxycycline (D, 30 µg/mL), erythromycin (E, 15 µg/mL), lincomycin (L, 15 µg/mL), novobiocin (NB, 5 µg/mL) and co-trimoxazole (COT, trimethoprim/sulfamethoxazole, 25 µg/mL) (HiMedia Laboratories Pvt. Ltd., Mumbai, India). Bacterial cultures were incubated overnight in Nutrient Broth (HiMedia Laboratories Pvt. Ltd., Mumbai, India) at 37 °C. Bacterial suspensions standardized to McFarland 0.5 were plated on Mueller–Hinton agar (HiMedia Laboratories Pvt. Ltd., Mumbai, India) Petri dishes and incubated at 37 °C for 24 h. Microorganisms were classified as susceptible (S), intermediate (I) or resistant (R) considering the interpretative criteria based on inhibition zone diameters (mm) around each disc according to the CLSI and EUCAST guidelines [36,37].
2.5. Estimation of Exoenzyme Activity, Motility and Pigment Production
Proteolytic, lipolytic and gelatinolytic enzyme production was evaluated by cultivation on Calcium caseinate agar, Spirit Blue agar (HiMedia Laboratories Pvt. Ltd., Mumbai, India) supplemented with 1% lipase reagent and Nutrient agar supplemented with gelatin (8 g/L), with incubation at 37 °C for 24, 48 and 72 h, respectively. The appearance of a clear halo around the bacterial growth was considered a positive reaction. For the visualization of gelatin hydrolysis, the surface was flooded with ammonium sulfate solution [38]. Aeromonas caviae A40/02 (positive) for alkaline protease production and Bacillus subtilis (positive) and Escherichia coli ATCC 25922 (negative) for gelatinase production were used as controls. Sialidase and sialate aldolase activities were determined by the colorimetric thiobarbiturate method [39]. Hyaluronidase production was assessed by the method of Patil and Chaudhari, 2017 [40]. Hemolytic activity was determined by inoculation on a Columbia blood agar Petri dish, supplemented with 5% defibrinated sheep blood (HiMedia Laboratories Pvt. Ltd., Mumbai, India). For the detection of urease activity, Christensen agar test tubes were used [41]. The motility of the strain was determined using stab inoculation on a motility test medium with 1% triphenyltetrazolium chloride (TTC) added [42].
Pigment production was detected qualitatively by a visual observation of the bacterial growth. The appearance of blue-green coloration was considered as pyocyanin (PCN) production. It was estimated during incubation at different temperatures, pH and salinity. The effect of temperature was evaluated at growth on Petri dishes with Cetrimide agar (Merck Group, Darmstadt, Germany) and incubation at 6 °C, 20 °C, 37 °C, 42 °C and 45 °C for 24 and 48 h. The effect of pH and salinity was recorded under the conditions in which bacterial growth curves were performed (see above mentioned). The presence of pyocyanin was also observed under UV light (366 nm), using UV-Box (Desaga Sarstedt-Gruppe, Wiesloch, Germany).
2.6. Crystal Violet Assay
The biofilm-forming capacity of the newly isolated strain P. aeruginosa was evaluated by a semi-quantitative in vitro assay using 96-well U-bottomed polystyrene microtiter plates (Corning, Corning, NY, USA) [43]. An 18 h bacterial culture grown overnight in Trypticase Soy Broth (HiMedia Laboratories Pvt. Ltd., Mumbai, India) at 37 °C was used as a start inoculum. Bacterial suspension with a concentration of 1 × 109 cells/mL was diluted 1:100 in M63 minimal salt medium (0.02 M KH2PO4, 0.04 M K2HPO4, 0.02 M (NH4)2SO4, 0.1 mM MgSO4 and 0.04 M glucose, pH 7.5). Aliquots of 150 µL of prepared suspension were loaded into the wells of the plates in 6 replicates. The plates were sealed with parafilm to prevent desiccation and incubated at 20 °C and 37 °C for 24 and 48 h, respectively, under static conditions. Non-adherent bacteria were discarded, and the wells were rinsed with Phosphate-buffered saline (PBS) before staining with 0.1% crystal violet followed by incubation at room temperature for 15 min. The unabsorbed dye was removed by rinsing the plates several times with PBS, and samples were solubilized with 70% ethanol. The absorbance of the solubilized samples was measured at 570 nm using a plate reader (INNO, Incheon, Republic of Korea). All experiments were conducted in duplicate, and the mean values were presented with standard deviations (SDs). Data analysis was carried out using Origin Pro 6.1. software (OriginLab Corporation, MA, USA).
2.7. Confocal Laser Scanning Microscopy (CLSM)
To determine bacterial viability in the biofilm community and some of its architectural characteristics, the fluorescence dye from the Live/Dead BacLight Bacterial Viability Kit (Invitrogen, Carlsbad, CA, USA) was applied. An 18 h culture of the strain was used as the initial inoculum. The cultivation was performed in 24-well plates on sterilized borosilicate cover glasses at 20 °C and 37 °C for 24 and 48 h. After the staining procedure recommended by the manufacturer, glass slides were mounted using Fluoromount Mounting Medium (Sigma, New York, NY, USA). For the analysis of biofilms by confocal laser scanning microscopy (CLSM) [44], Nikon Eclipse TiU with laser excitation wavelengths of 488 nm and emission at 543 nm in epifluorescence mode was used. Images were captured by a CCD camera, Nikon DS-Fi1 (Melville, NY, USA), and the two spectra were overlapped using NIS-Elements software (Ver. 4.0) and processed by the Icy bio-imaging program (Ver. GPLv3).
3. Results
3.1. Identification
BLAST analysis tools in the NCBI database were employed to confirm species status. Molecular identification indicated that the strain belonged to the species P. aeruginosa. The sequence obtained (1324 bp) was deposited in the Genbank, NCBI database under Acc. No. PP816020.1. P. aeruginosa PM1012. (The phylogenetic tree was represented in Figure S1 in Supplementary Materials).
3.2. Effect of Temperature, pH and Salinity on Bacterial Growth
Bacterial growth curves were performed at five different temperatures—6 °C, 20 °C, 37 °C, 42 °C and 45 °C—for 24 h. No growth was observed at 6 °C. At 37 °C, 42 °C and 45 °C, the lag phase was almost the same in duration and lasted about 2 h, while at 20 °C, it was prolonged to 3 1/2 h. Obviously, at the three higher temperatures, the growth curves moved in parallel and reached a stationary phase at about 15 h, while at 20 °C—about 18 h. OD values for the exponential phase at 20 °C were lower than the other three (Figure 1a).
Figure 1.
Growth of P. aeruginosa PM1012 depending on (a) temperature, (b) pH and (c) salinity.
The pH dependance of the growth was recorded at three time-points—6, 18 and 24 h (Figure 1b). No growth was observed at pH 4.0 and below. At pH 5.0 and 11.0, no growth was recorded at 6 h, but it appeared at 18 h. At the three time-points, the optimum pH was between pH 6.0 and 9.0 with a slight peak at pH 8.0.
The effect of salinity on growth was evaluated at the same time-points as pH dependance. No growth was registered above 6% salinity at the three time-points. (Figure 1c). Intense growth was visible up to 2% salinity. Negligible growth also occurred at 4% salinity but not until 18 h of cultivation.
3.3. Antibiotic Susceptibility
The antimicrobial susceptibility profile of the newly isolated strain P. aeruginosa PM1012 against a panel of antibiotics is presented in Figure 2. As might be expected, the strain showed natural resistance to antibiotics from different classes. Apart from intrinsic resistance, a high susceptibility rate was observed. Regarding β-lactams, resistance to meropenem, as well as intermediate sensitivity to third-generation cephalosporin ceftazidime and monobactam aztreonam, was found. Susceptibility to the other β-lactams from the carboxypenicillin and ureidopenicillin group (carbenicillin, ticarcillin, piperacillin/tazobactam), as well as to tested aminoglycosides, fluoroquinolones and chloramphenicol, was recorded.
Figure 2.
Antibiotic susceptibility pattern of P. aeruginosa PM1012. Legend: green—susceptible; yellow—intermediate; red—resistant; amoxicillin/clavulanic acid (AMC), carbenicillin (CB), ticarcillin (TI), ticarcillin/ clavulanic acid (TCC), piperacillin/tazobactam (PIT), cefotaxime (CT), ceftriaxone (CFT), ceftazidime (CAZ), aztreonam (AT), meropenem (MER), amikacin (AM), gentamycin (G), tobramycin (TB), pefloxacin (PF), ciprofloxacin (CP), levofloxacin (LE), chloramphenicol (C), tetracycline (T), doxycycline (D), erythromycin (E), lincomycin (L), novobiocin (NB), co-trimoxazole (COT).
3.4. Expression of Virulence Factors
3.4.1. Extracellular Enzyme Production
In P. aeruginosa PM1012, a positive reaction for protease, lipase and gelatinase production was expressed (Figure 3). The halo around the bacterial growth was visible at 24 h of cultivation but more clearly formed after 48 h (lipase, gelatinase). Neither sialidase nor urease or hemolytic activity was detected.
Figure 3.
Exoenzyme activity of P. aeruginosa PM1012: (a) protease; (b) lipase; (c) gelatinase and (d) motility.
The motility of the strain was evident after cultivation at 37 °C for 24 h by the formation of a cone-like red haze near the surface of the agar.
3.4.2. Pigment Production
The newly isolated P. aeruginosa PM1012 strain was shown to be a pyocyanin producer. Pyocyanin (PCN) production was observed to be stimulated at different temperatures. At 24 h, blue-green coloration was observed in samples cultivated at 37 °C (most intense), 42 °C and 45 °C, and no such color was visible at 20 °C. At 48 h, a clear green coloration appeared in the sample cultivated at 20 °C, while the coloration in other samples changed to red-brown (again most intense at 37 °C), possibly due to displacement by another pigment, perhaps pyorubin (Figure 4a,b). PCN production was clearly visible under UV light (366 nm) as well. Bright fluorescence was observed at 24 h of cultivation. At 48 h, there was no streak fluorescence, when it is assumed that pyocyanin was already displaced by another pigment (Figure 4c,d).
Figure 4.
Pyocyanin production of P. aeruginosa PM1012: (a) at 24 h of cultivation; (b) at 48 h of cultivation; (c) at 37 °C for 24 h under UV light; (d) at 37 °C for 48 h under UV light; (e) dependent on pH; (f) dependent on salinity.
PCN production was visibly coincident with the optimum pH range. It was absent at an acidity below pH 5.0 (Figure 4e) and was weaker at pH 11.0.
PCN production was found to be tolerant only to low salinity—not exceeding 0.5% (Figure 4f)—although bacterial growth was observed at higher salinity also.
3.5. Biofilm Formation
3.5.1. Effect of Temperature on Biofilm Formation
In our previous study, the newly isolated strain of P. aeruginosa demonstrated an excellent biofilm-forming capacity at 37 °C for 24 h among a broad set of Gram-negative bacteria isolated from reptiles [45]. In the current study, we expanded research considering the effect of temperature during two different time intervals. The obtained results showed an increased biofilm production at 20 °C than that at 37 °C. Also, biofilm biomass was higher at 20 °C after 24 h with a value of 2.85 ± 0.09 compared to the same temperature at 48 h of cultivation with a value of 2.41 ± 0.14 (Figure 5).
Figure 5.
Temperature-dependent variations in biofilm formation by P. aeruginosa PM1012.
3.5.2. Effect of Temperature on Biofilm Viability and Architecture
Using microscopic methods, changes in the viability of bacterial cells and biofilm architecture were determined. Observation in epifluorescence mode with a 60X oil PlanApo objective (Nikon DS-Fi1, Melville, NY, USA) found the formation of a dense biofilm composed of a large number of cells after cultivation at 20 °C for 24 h. Structurally, a multi-layered biofilm composed primarily of live, green-stained intact bacterial cells was identified. Additionally, islands of biofilm consortia, also known as mushroom-like structures, were noted (indicated by white arrows in Figure 6). In contrast, optical sections obtained at the same temperature but after 48 h showed a certain loosening of the biofilm structure and the presence of consortia composed of dead, red-stained cells (indicated by white triangles in Figure 6). Also, single non-viable bacterial cells were also noticeable. These microscopic observations corresponded with the quantitative results from the crystal violet assays, highlighting the higher density and viability of the cells within the biofilms at 20 °C for 24 h.
Figure 6.
Cell viability of P. aeruginosa PM1012 within biofilms (white arrows point to islands of biofilm consortia containing live, green-stained bacterial cells; white triangles—biofilm consortia consisting of dead, red-stained cells). Scale bars = 50 μm.
4. Discussion
Possessing high pathogenicity and adaptivity, attributed mainly to (i) versatility in gene expression; (ii) the development of acquired and intrinsic resistance mechanisms against a wide range of antimicrobials; (iii) the production of an arsenal of virulence factors and (iv) biofilm-forming ability, P. aeruginosa is considered a microorganism of great importance to human and animal health. It adapts through genotypic and phenotypic alterations to evade antibiotics and host immune systems [8]. P. aeruginosa is intrinsically resistant to many structurally unrelated classes of antibiotics and capable of acquiring resistance to a number of effective antimicrobial agents, resulting in the emergence of MDR strains insensitive to one or more antibiotics in at least three or more antibiotic classes [8,46]. The responsible mechanisms, which can occur simultaneously or in various combinations, are as follows: the reduced permeability of the outer cell membrane; the overexpression of efficient efflux transport systems; the existence of chromosomal genes encoding enzymes that inactivate drugs; R-plasmids and integrons [47,48,49]. Organisms with a multiple antibiotic resistance (MAR) index greater than ≥0.2 suggest the presence of plasmids containing one or more resistance genes, each encoding an antibiotic resistance phenotype [50]. The so called wild-type P. aeruginosa phenotype is characterized by natural resistance to aminopenicillines and early cephalosporines, conferred by the production of cephalosporinase and by susceptibility to penicillins (ticarcillin, piperacillin), cephalosporins (ceftazidime, cefepime), monobactams (aztreonam) and carbapenems (imipenem, meropenem), aminoglycosides and fluoroquinolones, which are commonly used to treat pseudomonal infections [47,48,51]. The antibiotic susceptibility pattern of the newly isolated strain P. aeruginosa PM1012 partly covers this phenotype being susceptible to a group of carboxypenicillins and ureidopenicillins, aminoglycosides and fluoroquinolones but exhibiting a meropenem-resistant and ceftazidime/aztreonam-intermediate profile. The low rate of resistance to antimicrobial agents recommended for defining the MDR phenotype of P. aeruginosa [46] suggests a phenotype closer to the wild-type [51 phenotype of the newly isolated strain. Resistance to carbapenems in P. aeruginosa is often driven by the interplay of well-known intrinsic, acquired and adaptive resistance mechanisms typically classified into three broad categories, drug transport, drug inactivation and target modification [52], including, for instance, the overexpression of AmpC β–lactamase, deactivation of the outer membrane protein OprD and increased production of multidrug efflux pumps like MexAB–OprM and MexXY–OprM [53]. MexAB-OprM and MexXY-OprM also operate with extensive substrate specificity: fluoroquinolones, β-lactams, macrolides, tetracyclines, aminoglycosides, lincomycin, chloramphenicol, novobiocin, etc. [8,47,48,49]. Some findings indicate that Pseudomonas strains recovered from healthy animals showed susceptibility to aminoglycosides and fluoroquinolones [30]. The acquisition of resistance mechanisms is more frequently observed among clinical isolates or those originating from anthropogenically affected habitats than among environmental ones [30,54,55]. Consistent with the fact that wild animals are not treated with antibiotics, wildlife is not expected to play a fundamental role in the emergence of antibiotic resistance [56].
Several exoenzymes are part of the arsenal of virulence factors, involved in the process of pathogenesis by facilitating adhesion to surfaces, breaking down the host’s physical barriers, modulating the immune response, etc. [57,58]. Our results indicate protease, lipase and gelatinase production by the strain P. aeruginosa PM1012. Bacterial proteases play an important role in the penetration and efficient propagation of pathogens within a host, participating in the destruction of cellular structures, reducing the integrity between tissues and inactivating the components of the host’s immune defense (e.g., immunoglobulin, IgA) [59,60,61]. Gelatinase is a protease capable of hydrolyzing gelatin, collagen, fibrinogen, fibrin, endothelin-1 and complement components C3 and C3a [62]. Bacterial lipases and phospholipases hydrolyze lipid components of host cell membranes as well as lung surfactant lipids, thereby aiding bacterial invasion [63,64]. The pathogenic effect of lipolytic enzymes is manifested not only through their direct hydrolytic action but also through their ability to influence various cell signaling pathways and modulate the immune response [63,65]. In addition, lipase A (LipA) interacts with alginate in the extracellular biofilm matrix produced by P. aeruginosa itself through electrostatic interactions, contributing to drug resistance [9]. Comparative analysis, in general, found a narrower range of enzyme diversity and a lower frequency of production in environmental P. aeruginosa isolates than in clinical isolates [66].
Our findings revealed that P. aeruginosa PM1012 is a strong pyocyanin producer. PCN production was visible in the range of the optimal conditions of growth. Pigment synthesis, especially of pyocyanin (PCN), is considered an important virulence factor in P. aeruginosa [67,68]. This phenazine compound is responsible for the blue-green coloration characteristic of P. aeruginosa and is considered both a virulence factor and a quorum sensing (QS) signaling molecule [69]. The low molecular weight and zwitterionic properties of PCN enables it to easily permeate cell membranes [70]. One of the most important biological roles of PCN is its ability to modulate redox cycling by oxidizing NADH and glutathione and generating reactive oxygen species (ROS), in particular superoxide (O2−) and hydrogen peroxide (H2O2), which are capable of causing significant oxidative stress that disrupts the cell’s metabolism and can lead to cell death [69,70,71]. It disrupts host catalase and the electron transport system (ETS) [70], inhibits cellular respiration and depletes intracellular cAMP and ATP levels [69]. PCN also alters the host’s immune response, being able to prevent the development of an effective T-cell response against P. aeruginosa, the activation of monocytes and macrophages (by inhibiting cytokine production) and lymphocyte proliferation, as well as increasing mucosal secretion [69,71]. Some studies indicate that, among multiple biological activities, pyocyanin can promote biofilm formation in P. aeruginosa through the PCN-mediated production of eDNA, which probably occurs as a consequence of cell lysis induced by H2O2 generation [70,72]. Acyl-homoserine lactone (AHL) autoinducers are also implicated in the regulation of PCN transcription, and their increase enhances it [73]. High/moderate levels of pyocyanin production are more common among environmental isolates than clinical ones [73]. In addition, pyocyanin-producing strains appear to be more virulent and more resistant to many drugs than non-pyocyanin-producing ones [68]. The limiting external factors in regulating pyocyanin production are nutrient levels and variations in pH, temperature and aeration [68,73].
Biofilm formation is a remarkable survival strategy employed by P. aeruginosa, providing physical protection from the host immune system; significantly higher resistance to antimicrobial agents; nutrient storage and high enzymatic activity and facilitated adhesion to infection sites, promoting persistent colonization [8,74,75]. Its spread has been associated with various surfaces including the lungs, burn wounds, diabetic feet, the cornea of the eye and medical devices contributing to infections resistant to conventional antibiotics [76]. During the passage of P. aeruginosa from the environment to the host, it encounters frequent temperature fluctuations. Different studies indicate that these temperature changes affect its protein profile, gene expression and biofilm formation [76,77]. However, the relationship between biofilm formation and temperature in animal isolates has not been previously documented. Considering the impact of temperature fluctuations in reptiles, we investigated how these changes affect one of the critical factors of virulence—biofilm formation by P. aeruginosa PM1012 at 20 °C and 37 °C during two different time intervals. The obtained results showed the highest biofilm productivity at 20 °C for 24 h. These findings align with other studies demonstrating the relationship between temperature and biofilm formation [77,78,79,80]. Similar temperature effects on biofilm formation were observed in our earlier studies with E. coli K-12 strains, where biofilm biomass accumulation increased in three of the strains at 20 °C [81].
Some studies note a relationship between pigment production, antibiotic resistance behavior and biofilm formation [10,82]. Possible connectivity between these features in P. aeruginosa PM1012 will be further investigated.
5. Conclusions
The present work examines various characteristics of a wild-type P. aeruginosa strain, isolated from the cloacal microbiota of a common wall lizard (P. muralis), living in its natural habitat. Some of the strain features, such as the production of pyocyanin and exoenzymes, as well as biofilm formation, are very poorly studied areas in bacteria isolated from wild animals but are important for establishing their pathogenic potential. The newly isolated strain P. aeruginosa PM1012 appeared to be an excellent biofilm and pyocyanin producer. Despite the limitations of this study, it contributes to the elucidation of the expression of virulence factors in bacteria recovered from natural niches. Since this microorganism is considered to be an important opportunistic pathogen, in the future, it would be advisable to expand the collection of P. aeruginosa isolates circulating in wild reptile populations and deepen studies in their comparative aspects.
Supplementary Materials
The following supporting information can be downloaded at https://www.mdpi.com/article/10.3390/applmicrobiol4030096/s1, Figure S1: Phylogenetic tree for P. aeruginosa PM1012 based on 16S rRNA data constructed with MEGA6.
Author Contributions
Conceptualization, I.L. and S.E.; methodology, I.L., S.E., S.M., M.G., T.P.-K. and R.E.; formal analysis, I.L., S.E., S.M., R.E., D.B., Y.G., T.P.-K. and M.G.; investigation, I.L., S.E., S.M., R.E., D.B., Y.G., T.P.-K. and M.G.; resources, I.L., E.V., N.S. and S.P.; data curation, I.L., R.E., T.P.-K. and M.G.; writing—original draft preparation, I.L. and S.E.; writing—review and editing, S.E., R.E. and Y.G.; visualization, I.L., R.E., T.P.-K. and M.G. All authors have read and agreed to the published version of the manuscript.
Funding
This research was funded by the Bulgarian National Science Fund of the Ministry of Education and Science (Project KP–06-M51/9, 22 November 2021).
Institutional Review Board Statement
The handling of animals was conducted in accordance with national legislation—Regulation 20/1 November 2012 for the minimal requirements and humane treatment in the breeding and use of experimental animals—and approval was granted by the Ministry of Environment and Water (Permit № 861/13.01.2021).
Data Availability Statement
Data are contained within this article or Supplementary Materials.
Conflicts of Interest
The authors declare no conflicts of interest. The funders had no role in the design of the study; in the collection, analyses, or interpretation of data; in the writing of the manuscript; or in the decision to publish the results.
References
- Diggle, S.; Whiteley, M. Microbe Profile: Pseudomonas aeruginosa: Opportunistic pathogen and lab rat. Microbiology 2020, 166, 30–33. [Google Scholar] [CrossRef] [PubMed]
- LaBauve, A.; Wargo, M. Growth and Laboratory Maintenance of Pseudomonas aeruginosa. Curr. Protoc. Microbiol. 2012, 25, 6E.1.1–6E.1.8. [Google Scholar] [CrossRef] [PubMed]
- Walker, T.; Bais, H.; Déziel, E.; Schweizer, H.; Rahme, L.; Fall, R.; Vivanco, J. Pseudomonas aeruginosa-Plant Root Interactions. Pathogenicity, Biofilm Formation, and Root Exudation. Plant Physiol. 2004, 134, 320–333. [Google Scholar] [CrossRef] [PubMed]
- Lupo, A.; Haenni, M.; Madec, J.Y. Antimicrobial resistance in Acinetobacter spp. and Pseudomonas spp. Microbiol. Spectr. 2018, 6, 377–393. [Google Scholar] [CrossRef] [PubMed]
- Morales-Espinosa, R.; Delgado, G.; Espinosa-Camacho, F.; Flores-Alanis, A.; Rodriguez, C.; Mendez, J.L.; Gonzalez-Pedraza, A.; Cravioto, A. Pseudomonas aeruginosa strains isolated from animal with high virulence genes content and highly sensitive to antimicrobials. J. Glob. Antimicrob. Resist. 2024, 37, 75–80. [Google Scholar] [CrossRef]
- Malhotra, S.; Hayes, D., Jr.; Wozniak, D.J. Cystic fibrosis and Pseudomonas aeruginosa: The host-microbe interface. Clin. Microbiol. Rev. 2019, 32, e00138-18. [Google Scholar] [CrossRef]
- Qin, S.; Xiao, W.; Zhou, C.; Pu, Q.; Deng, X.; Lan, L.; Liang, H.; Song, X.; Wu, M. Pseudomonas aeruginosa: Pathogenesis, virulence factors, antibiotic resistance, interaction with host, technology advances and emerging therapeutics. Signal Transduct. Target Ther. 2022, 7, 199. [Google Scholar] [CrossRef]
- Elfadadny, A.; Ragab, R.; Al Harbi, M.; Badshah, F.; Ibáñez-Arancibia, E.; Farag, A.; Hendawy, A.; De los Ríos-Escalante, P.R.; Aboubakr, M.; Zakai, S.; et al. Antimicrobial resistance of Pseudomonas aeruginosa: Navigating clinical impacts, current resistance trends, and innovations in breaking therapies. Front. Microbiol. 2024, 15, 1374466. [Google Scholar] [CrossRef]
- Liao, C.; Huang, X.; Wang, Q.; Yao, D.; Lu, W. Virulence Factors of Pseudomonas aeruginosa and Antivirulence Strategies to Combat Its Drug Resistance. Front. Cell. Infect. Microbiol. 2022, 12, 926758. [Google Scholar] [CrossRef]
- Edward, E.A.; El Shehawy, M.R.; Abouelfetouh, A.; Aboulmagd, E. Prevalence of different virulence factors and their association with antimicrobial resistance among Pseudomonas aeruginosa clinical isolates from Egypt. BMC Microbiol. 2023, 23, 161. [Google Scholar] [CrossRef]
- Weimann, A.; Dinan, A.; Ruis, C.; Bernut, A.; Pont, S.; Brown, K.; Ryanm, J.; Santos, L.; Ellison, L.; Ukor, E.; et al. Evolution and host-specific adaptation of Pseudomonas aeruginosa. Science 2024, 385, eadi0908. [Google Scholar] [CrossRef] [PubMed]
- Eliasi, U.; Sebola, D.; Oguttu, J.; Qekwana, D. Antimicrobial resistance patterns of Pseudomonas aeruginosa isolated from canine clinical cases at a veterinary academic hospital in South Africa. J. South Afr. Vet. Assoc. 2020, 91, 1–6. [Google Scholar] [CrossRef]
- Gigante, A.; Hadis, M.; Secker, B.; Shaw, S.; Cooper, P.; Palin, W.; Milward, M.; Atterbury, R. Exposure to blue light reduces antimicrobial resistant Pseudomonas aeruginosa isolated from dog ear infections. Front. Microbiol. 2024, 15, 1414412. [Google Scholar] [CrossRef] [PubMed]
- Salomonsen, C.; Themudo, G.; Jelsbak, L.; Molin, S.; Høiby, N.; Hammer, A. Typing of Pseudomonas aeruginosa from hemorrhagic pneumonia in mink (Neovison vison). Vet. Microbiol. 2013, 163, 103–109. [Google Scholar] [CrossRef] [PubMed]
- Bai, J.; Wang, X.; Zhang, Z.; Lian, P.; Qiao, J. Overview of Mink Immunity and Resistance to Pseudomonas aeruginosa. Vet. Med. Int. 2023, 1, 6158844. [Google Scholar] [CrossRef]
- Schauer, B.; Wald, R.; Urbantke, V.; Loncaric, I.; Baumgartner, M. Tracing Mastitis Pathogens -Epidemiological Investigations of a Pseudomonas aeruginosa Mastitis Outbreak in an Austrian Dairy Herd. Animals 2021, 11, 279. [Google Scholar] [CrossRef]
- Abd El-Ghany, W. Pseudomonas aeruginosa infection of avian origin: Zoonosis and one health implications. Vet. World 2021, 14, 2155–2159. [Google Scholar] [CrossRef]
- Ebani, V.; Fratini, F.; Ampola, M.; Rizzo, E.; Cerri, D.; Andreani, E. Pseudomonas and Aeromonas isolates from domestic reptiles and study of their antimicrobial in vitro sensitivity. Vet. Res. Commun. 2008, 32, 195–198. [Google Scholar] [CrossRef]
- Divers, S. Bacterial Diseases of Reptiles, MSD Veterinary Manual. 2022. Available online: https://www.msdvetmanual.com/exotic-and-laboratory-animals/reptiles/bacterial-diseases-of-reptiles (accessed on 22 February 2024).
- Sala, A.; Di Ianni, F.; Pelizzone, I.; Bertocchi, M.; Santospirito, D.; Rogato, F.; Flisi, S.; Spadini, C.; Iemmi, T.; Moggia, E.; et al. The prevalence of Pseudomonas aeruginosa and multidrug resistant Pseudomonas aeruginosa in healthy captive ophidian. PeerJ 2019, 7, e6706. [Google Scholar] [CrossRef]
- Batista, A.; Pereira, L.; de Melo Neto, J.; dos Santos, T.; de Souza Araújo, Í.; da Silva, J.; Júnior, F. Vesicular dermatitis caused by multiresistent Pseudomonas spp. in the carpet python (Morelia spilota Lacepede, 1804) (Squamata: Pythonidae)—Case report. Res. Soc. Dev. 2021, 10, e205101320966. [Google Scholar] [CrossRef]
- Martins, N.; Ferreira, L.; Queiroz, C.; Buiatte, A.; Lima, A.; De Souza, R.; Oliveira, W., Jr.; Santos, A. Caseous stomatitis caused by Pseudomonas aeruginosa in Boa constrictor amarali. Acta Sci. Vet. 2021, 49, 615. [Google Scholar] [CrossRef]
- Šupić, J.; Rešidbegović, E.; Koro, A.; Hadžiabdić, S.; Golob, M.; Škapur, V.; Alić, A. Fatal Disseminated Pseudomonas aeruginosa Infection in a Captive Green Iguana (Iguana iguana). Acta Vet. 2021, 71, 361–370. [Google Scholar] [CrossRef]
- Xiong, Y.; Wu, Q.; Qin, X.; Yang, C.; Luo, S.; He, J.; Cheng, Q.; Wu, Z. Identification of Pseudomonas aeruginosa from the skin ulcer disease of crocodile lizards (Shinisaurus crocodilurus) and probiotics as the control measure. Front. Vet. Sci. 2022, 9, 850684. [Google Scholar] [CrossRef] [PubMed]
- Liu, P.; Weng, L.; Tseng, S.; Huang, C.; Cheng, C.; Mao, Y.; Tung, K. Colistin resistance of Pseudomonas aeruginosa isolated from snakes in Taiwan. Can. J. Infect. Dis. Med. Microbiol. 2017, 2017, 7058396. [Google Scholar] [CrossRef]
- Foti, M.; Giacopello, C.; Fisichella, V.; Latella, G. Multidrug-resistant Pseudomonas aeruginosa isolates from captive reptiles. J. Exot. Pet Med. 2013, 22, 270–274. [Google Scholar] [CrossRef]
- Muñoz-Ibarra, E.; Molina-López, R.A.; Durán, I.; Garcias, B.; Martín, M.; Darwich, L. Antimicrobial resistance in bacteria isolated from exotic pets: The situation in the Iberian Peninsula. Animals 2022, 125, 1912. [Google Scholar] [CrossRef]
- Wendt, M.; De Silva, B.; Heo, G.J. Virulence Factors and Antimicrobial Resistance of Pseudomonas aeruginosa Isolated from Pet Turtles. Asian J. Anim. Vet. Adv. 2017, 12, 205–211. [Google Scholar] [CrossRef][Green Version]
- Wickramanayake, M.; De Silva, L.; Heo, G.-J. Pseudomonas aeruginosa from pet Chinese stripe-necked turtles (Ocadia sinensis) demonstrating antimicrobial and heavy metal resistance. Vet. Integr. Sci. 2022, 20, 761–773. [Google Scholar] [CrossRef]
- Ruiz-Roldán, L.; Rojo-Bezares, B.; de Toro, M.; López, M.; Toledano, P.; Lozano, C.; Chichon, G.; Alvarez-Erviti, L.; Torres, C.; Saenz, Y. Antimicrobial resistance and virulence of Pseudomonas spp. among healthy animals: Concern about exolysin ExlA detection. Sci. Rep. 2020, 10, 11667. [Google Scholar] [CrossRef]
- Weisburg, W.; Barns, S.; Pelletier, D.; Lane, D. 16S ribosomal DNA amplification for phylogenetic study. J. Bacteriol. 1991, 173, 697–703. [Google Scholar] [CrossRef]
- Hall, T. BioEdit: A user-friendly biological sequence alignment editor and analysis program for Windows 95/98/NT. Nucleic Acids. Symp. Ser. 1999, 41, 95–98. Available online: https://api.semanticscholar.org/CorpusID:82421255 (accessed on 30 January 2024).
- Camacho, C.; Coulouris, G.; Avagyan, V.; Ma, N.; Papadopoulos, J.; Bealer, K.; Madden, T. BLAST+: Architecture and applications. BMC Bioinform. 2009, 10, 421. [Google Scholar] [CrossRef] [PubMed]
- Abel, E.; Evivie, S. Effect of varying environmental conditions on the growth and viability of selected microorganisms using conventional cultures. J. Appl. Sci. Environ. Manag. 2022, 26, 393–397. [Google Scholar] [CrossRef]
- Hudzicki, J. Kirby-Bauer Disk Diffusion Susceptibility Test Protocol, American Society for Microbiology. 2009. Available online: https://asm.org/getattachment/2594ce26-bd44-47f6-8287-0657aa9185ad/Kirby-Bauer-Disk-Diffusion-Susceptibility-Test-Protocol-pdf.pdf (accessed on 11 November 2023).
- CLSI Guidelines M100—M02. In Performance Standards for Antimicrobial Susceptibility Testing, 33rd ed.; Clinical Laboratory Standards Institute: Wayne, PA, USA, 2023.
- The European Committee on Antimicrobial Susceptibility Testing (EUCAST). Breakpoint Tables for Interpretation of MICs and Zone Diameters, Version 14.0. 2024. Available online: http://www.eucast.org (accessed on 14 February 2024).
- dela Cruz, T.; Torres, J. Gelatin Hydrolysis Test Protocol, American Society for Microbiology. 2012. Available online: https://asm.org/ASM/media/Protocol-Images/Gelatin-Hydrolysis-Test-Protocol.pdf?ext=.pdf (accessed on 15 November 2023).
- Uchida, Y.; Tsukada, Y.; Sugimori, T. Distribution of neuraminidase in Arthrobacter and its purification by affinity chromatography. J. Biochem. 1977, 82, 1425–1433. [Google Scholar] [CrossRef] [PubMed]
- Patil, S.; Chaudhari, B. A simple, rapid and sensitive plate assay for detection of microbial hyaluronidase activity. J. Basic Microbiol. 2017, 57, 358–361. [Google Scholar] [CrossRef] [PubMed]
- Brink, B. Urease Test Protocol, American Society for Microbiology. 2010. Available online: https://asm.org/getattachment/ac4fe214-106d-407c-b6c6-e3bb49ac6ffb/urease-test-protocol-3223.pdf (accessed on 9 April 2024).
- Shields, P.; Cathcart, L. Motility Test Medium Protocol, American Society for Microbiology. 2011. Available online: https://asm.org/ASM/media/Protocol-Images/Motility-Test-Medium-Protocol.pdf?ext=.pdf (accessed on 15 April 2024).
- Merritt, J.; Kadouri, D.; O’Toole, G. Growing and analyzing static biofilms. Curr. Protoc. Microbiol. 2005, 1, 853. [Google Scholar] [CrossRef]
- Zhang, P.; Chen, Y.; Qiu, J.; Dai, Y.; Feng, B. Imaging the Microprocesses in Biofilm Matrices. Trends Biotechnol. 2019, 37, 214–226. [Google Scholar] [CrossRef]
- Lazarkevich, I.; Engibarov, S.; Mitova, S.; Popova, S.; Vacheva, E.; Stanchev, N.; Eneva, R.; Gocheva, Y.; Lalovska, I.; Paunova-Krasteva, T.; et al. Pathogenic Potential of Opportunistic Gram-Negative Bacteria Isolated from the Cloacal Microbiota of Free-Living Reptile Hosts Originating from Bulgaria. Life 2024, 14, 566. [Google Scholar] [CrossRef]
- Magiorakos, A.; Srinivasan, A.; Carey, R.; Carmeli, Y.; Falagas, M.; Giske, C.; Harbarth, S.; Hindler, J.; Kahlmeter, G.; Olsson-Liljequist, B.; et al. Multidrug-resistant, extensively drug-resistant and pandrug-resistant bacteria: An international expert proposal for interim standard definitions for acquired resistance. Clin. Microbiol. Infect. 2012, 18, 268–281. [Google Scholar] [CrossRef]
- Morita, Y.; Tomida, J.; Kawamura, Y. Responses of Pseudomonas aeruginosa to antimicrobials. Front. Microbiol. 2014, 4, 422. [Google Scholar] [CrossRef]
- Strateva, T.; Yordanov, D. Pseudomonas aeruginosa—A phenomenon of bacterial resistance. J. Med. Microbiol. 2009, 58, 1133–1148. [Google Scholar] [CrossRef] [PubMed]
- Avakh, A.; Grant, G.; Cheesman, M.; Kalkundri, T.; Hall, S. The art of war with Pseudomonas aeruginosa: Targeting Mex efflux pumps directly to strategically enhance antipseudomonal drug efficacy. Antibiotics 2023, 12, 1304. [Google Scholar] [CrossRef] [PubMed]
- Afunwa, R.; Ezeanyinka, J.; Afunwa, E.; Udeh, A.; Oli, N.; Unachukwu, M. Multiple Antibiotic Resistant Index of Gram-Negative Bacteria from Bird Droppings in Two Commercial Poultries in Enugu, Nigeria. Open J. Med. Microbiol. 2020, 10, 171–181. [Google Scholar] [CrossRef]
- Bălăşoiu, M.; Bălăşoiu, A.; Mănescu, R.; Avramescu, C.; Ionete, O. Pseudomonas aeruginosa resistance phenotypes and phenotypic highlighting methods. Curr. Health Sci. J. 2014, 40, 85. [Google Scholar] [CrossRef] [PubMed]
- Salvà-Serra, F.; Jaén-Luchoro, D.; Marathe, N.; Adlerberth, I.; Moore, E.; Karlsson, R. Responses of carbapenemase-producing and non-producing carbapenem-resistant Pseudomonas aeruginosa strains to meropenem revealed by quantitative tandem mass spectrometry proteomics. Front. Microbiol. 2023, 13, 1089140. [Google Scholar] [CrossRef]
- Gobezie, M.; Hassen, M.; Tesfaye, N.; Solomon, T.; Demessie, M.; Kassa, T.; Wendie, T.; Andualem, A.; Alemayehu, E.; Belayneh, Y. Prevalence of meropenem-resistant Pseudomonas aeruginosa in Ethiopia: A systematic review and me-ta analysis. Antimicrob. Resist. Infect. Control. 2024, 13, 37. [Google Scholar] [CrossRef]
- Ramsay, K.; Wardell, S.; Patrick, W.; Brockway, B.; Reid, D.; Winstanley, C.; Bell, S.; Lamont, I. Genomic and phenotypic comparison of environmental and patient-derived isolates of Pseudomonas aeruginosa suggest that antimicrobial resistance is rare within the environment. J. Med. Microbiol. 2019, 68, 1591–1595. [Google Scholar] [CrossRef]
- Streeter, K.; Katouli, M. Pseudomonas aeruginosa: A review of their pathogenesis and prevalence in clinical settings and the environment. Infect. Epidemiol. Med. 2016, 2, 25–32. [Google Scholar] [CrossRef]
- Laborda, P.; Sanz-García, F.; Ochoa-Sánchez, L.; Gil-Gil, T.; Hernando-Amado, S.; Martínez, J. Wildlife and antibiotic resistance. Front. Cell. Infec. Microbiol. 2022, 12, 873989. [Google Scholar] [CrossRef]
- Traving, C.; Schauer, R. Structure, function and metabolism of sialic acids. Cell. Mol. Life Sci. 1998, 54, 1330–1349. [Google Scholar] [CrossRef]
- Sangeetha, A.; Abdel-hadi, A.; Hassan, A.; Shobana, C.; Suresh, S.; Abirami, B.; Selvam, K.; Al-Baradie, R.; Banawas, S.; Alaidarous, M.; et al. Evaluation of in vitro activities of extracellular enzymes from Aspergillus species isolated from corneal ulcer/keratitis. Saudi J. Biol. Sci. 2020, 27, 701–705. [Google Scholar] [CrossRef] [PubMed]
- Lantz, M. Are Bacterial proteases important virulence factors? J. Periodontal Res. 1997, 32, 126–132. [Google Scholar] [CrossRef] [PubMed]
- Figaj, D.; Ambroziak, P.; Przepiora, T.; Skorko-Glonek, J. The role of proteases in the virulence of plant pathogenic bacteria. Int. J. Mol. Sci. 2019, 20, 672. [Google Scholar] [CrossRef] [PubMed]
- Zhigis, L.; Kotelnikova, O.; Zinchenko, A.; Karlinsky, D.; Prokopenko, Y.; Rumsh, L. IgA1 protease as a vaccine basis for prevention of bacterial meningitis. Russ. J. Bioorg. Chem. 2021, 47, 805–814. [Google Scholar] [CrossRef]
- Thurlow, L.; Thomas, V.; Narayanan, S.; Olson, S.; Fleming, S.; Hancock, L. Gelatinase contributes to the pathogenesis of endocarditis caused by Enterococcus faecalis. Infect. Immun. 2010, 78, 4936–4943. [Google Scholar] [CrossRef] [PubMed]
- Bender, J.; Flieger, A. Lipases as pathogenicity factors of bacterial pathogens of humans. In Handbook of Hydrocarbon and Lipid Microbiology; Timmis, K., Ed.; Springer: Berlin/Heidelberg, Germany, 2010; pp. 3241–3258. [Google Scholar] [CrossRef]
- Zhang, Z.; Zhang, X. Evolution of Subfamily I.1 Lipases in Pseudomonas aeruginosa. Curr. Microbiol. 2021, 78, 3494–3504. [Google Scholar] [CrossRef]
- Jaeger, K.; Ransac, S.; Dijkstra, B.; Colson, C.; van Heuvel, M.; Misset, O. Bacterial lipases. FEMS Microbiol. Rev. 1994, 15, 29–63. [Google Scholar] [CrossRef]
- Aqel, H.; Sannan, N.; Foudah, R.; Al-Hunaiti, A. Enzyme Production and Inhibitory Potential of Pseudomonas aeruginosa: Contrasting Clinical and Environmental Isolates. Antibiotics 2023, 12, 1354. [Google Scholar] [CrossRef]
- da Cruz Nizer, W.; Inkovskiy, V.; Versey, Z.; Strempel, N.; Cassol, E.; Overhage, J. Oxidative Stress Response in Pseudomonas aeruginosa. Pathogens 2021, 10, 1187. [Google Scholar] [CrossRef]
- Abdelaziz, A.; Kamer, A.; Al-Monofy, K.; Al-Madboly, L. Pseudomonas aeruginosa’s greenish-blue pigment pyocyanin: Its production and biological activities. Microb. Cell Fact. 2023, 22, 110. [Google Scholar] [CrossRef]
- Ho Sui, S.J.; Lo, R.; Fernandes, A.R.; Caulfield, M.D.; Lerman, J.A.; Xie, L.; Bourne, P.E.; Baillie, D.L.; Brinkman, F.S. Raloxifene attenuates Pseudomonas aeruginosa pyocyanin production and virulence. Int. J. Antimicrob. Agents 2012, 40, 246–251. [Google Scholar] [CrossRef] [PubMed]
- Hall, S.; McDermott, C.; Anoopkumar-Dukie, S.; McFarland, A.J.; Forbes, A.; Perkins, A.V.; Davey, A.K.; Chess-Williams, R.; Kiefel, M.J.; Arora, D.; et al. Cellular Effects of Pyocyanin, a Secreted Virulence Factor of Pseudomonas aeruginosa. Toxins 2016, 8, 236. [Google Scholar] [CrossRef] [PubMed]
- Jabłońska, J.; Augustyniak, A.; Dubrowska, K.; Rakoczy, R. The two faces of pyocyanin–why and how to steer its production? World J. Microbiol. Biotechnol. 2023, 39, 103. [Google Scholar] [CrossRef] [PubMed]
- Das, T.; Manefield, M. Pyocyanin Promotes Extracellular DNA Release in Pseudomonas aeruginosa. PLoS ONE 2012, 7, e46718. [Google Scholar] [CrossRef] [PubMed]
- Shouman, H.; Said, H.; Kenawy, H.; Hassan, R. Molecular and biological characterization of pyocyanin from clinical and environmental Pseudomonas aeruginosa. Microb. Cell Fact. 2023, 22, 166. [Google Scholar] [CrossRef]
- Vestby, L.; Grønseth, T.; Simm, R.; Nesse, L. Bacterial biofilm and its role in the pathogenesis of disease. Antibiotics 2020, 9, 59. [Google Scholar] [CrossRef]
- Singh, S.; Singh, S.; Chowdhury, I.; Singh, R. Understanding the mechanism of bacterial biofilms resistance to antimicrobial agents. Open Microbiol. J. 2017, 11, 53–62. [Google Scholar] [CrossRef]
- Bisht, K.; Moore, J.; Caprioli, R.; Skaar, E.; Wakeman, C. Impact of temperature-dependent phage expression on Pseudomonas aeruginosa biofilm formation. Npj Biofilms Microbiomes 2021, 7, 22. [Google Scholar] [CrossRef]
- Al-Khazraji, S.; Al-Maeni, M. Optimization of some environmental and nutritional conditions using microtiter plate for Pseudomonas aeruginosa biofilm formation. J. Anim. Behav. Biometeorol. 2021, 9, 2136. [Google Scholar] [CrossRef]
- Choi, N.; Kim, B.; Bae, Y.; Lee, S. Biofilm formation, attachment, and cell hydrophobicity of foodborne pathogens under varied environmental conditions. J. Korean Soc. Appl. Biol. Chem. 2013, 56, 207–220. [Google Scholar] [CrossRef]
- Iliadis, I.; Daskalopoulou, A.; Simoes, M.; Giaouris, E. Integrated combined effects of temperature, pH and sodium chloride concentration on biofilm formation by Salmonella enterica ser. enteritidis and typhimurium under low nutrient food-related conditions. Food Res. Int. 2018, 107, 10–18. [Google Scholar] [CrossRef] [PubMed]
- De Silva, P.; Chong, P.; Fernando, D.; Westmacott, G.; Kumar, A. Effect of incubation temperature on antibiotic resistance and virulence factors of Acinetobacter baumanii ATCC 17978. Antimicrob. Agents Chemother. 2018, 62, e01514-17. [Google Scholar] [CrossRef] [PubMed]
- Borisova, D.; Jordanova, V.; Stoitsova, S.; Paunova-Krasteva, T. Impact of Growth Conditions on Biofilm Formation by Model Gram- Negative and Gram-Positive Bacterial Strains. Acta Microbiol. Bulg. 2019, 35, 60–65. [Google Scholar]
- Kothari, A.; Kumar, S.K.; Singh, V.; Kumar, P.; Kaushal, K.; Pandey, A.; Jain, N.; Omar, B.J. Association of multidrug resistance behavior of clinical Pseudomonas aeruginosa to pigment coloration. Eur. J. Med. Res. 2022, 27, 120. [Google Scholar] [CrossRef] [PubMed]
Disclaimer/Publisher’s Note: The statements, opinions and data contained in all publications are solely those of the individual author(s) and contributor(s) and not of MDPI and/or the editor(s). MDPI and/or the editor(s) disclaim responsibility for any injury to people or property resulting from any ideas, methods, instructions or products referred to in the content. |
© 2024 by the authors. Licensee MDPI, Basel, Switzerland. This article is an open access article distributed under the terms and conditions of the Creative Commons Attribution (CC BY) license (https://creativecommons.org/licenses/by/4.0/).